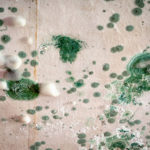

CERTIFIED
Many contractors build over mold because mold is not always noticeable.
The Construction Doctor not only provides remodeling services but also offers Mold Remediation through a healthy and safe Eco-Friendly process of removing and cleaning up mold contamination in interior or exterior areas.
LOS ANGELES COUNTY • ORANGE COUNTY • RIVERSIDE COUNTY • SAN BERNARDINO COUNTY • ALL NON-INCORPORATED AREAS. GIVE US A CALL1(888) 610-6364
LET OUR TEAM OF PROFESSIONALS TAKE CARE OF YOUR PROPERTY
THE CONSTRUCTIONDOCTOR
The Construction Doctor works to restore your property to its newest and/or pre-loss state with highly qualified professionals that are trained to perform excellent service no matter how big or small the project!
WHATPEOPLE SAYS
Jennifer Walker
Customer Great service, had an emergency water damage, they got here right away, and took care of everything, including drywall, carpet removal, and left all required dryers for a faster result.
John Gutierrez
CustomerI was in need of a patio cover, not only am satisfied with their services, but also how I was treated like a family member, made everything more comfortable and pleasant, they met my budget, very affordable.
HAPPY CUSTOMERS
ALWAYS ON-TIME
EMERGENCY CALLS
24HR EMERGENCY AVAILABLE
1(888) 610-6364